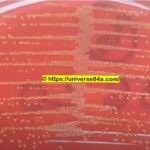
Staphylococcus lentus colomy morphology on CLED agar of old man Urine culture_

Tag: Biofilm-related resistance
Staphylococcus lentus: Introduction, Morphology, Pathogenicity, Lab Diagnosis, Treatment,Prevention, and Keynotes
 Introduction Staphylococcus lentus is a species of Gram-positive bacteria that...
Introduction Staphylococcus lentus is a species of Gram-positive bacteria that...
Introduction Staphylococcus lentus is a species of Gram-positive bacteria that...
Introduction Staphylococcus lentus is a species of Gram-positive bacteria that...